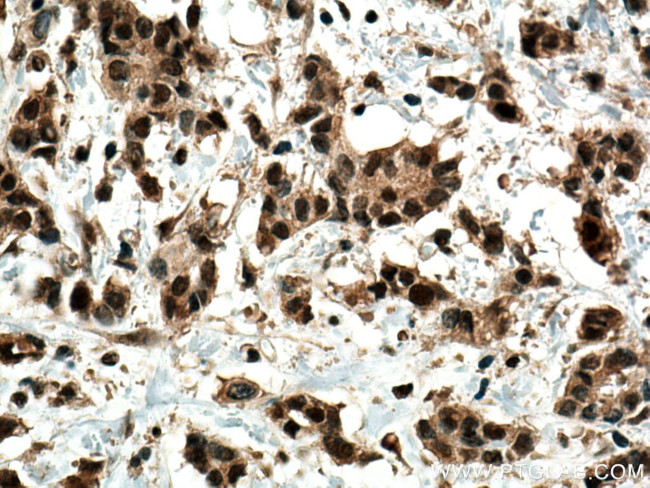
GLI2 Antibody in Immunohistochemistry (Paraffin) (IHC (P))

Search
Proteintech
GLI2 Polyclonal Antibody
{{$productOrderCtrl.translations['antibody.pdp.commerceCard.promotion.promotions']}}
{{$productOrderCtrl.translations['antibody.pdp.commerceCard.promotion.viewpromo']}}
{{$productOrderCtrl.translations['antibody.pdp.commerceCard.promotion.promocode']}}: {{promo.promoCode}} {{promo.promoTitle}} {{promo.promoDescription}}. {{$productOrderCtrl.translations['antibody.pdp.commerceCard.promotion.learnmore']}}
产品信息
28245-1-AP
种属反应
宿主/亚型
分类
类型
抗原
偶联物
形式
浓度
规格
纯化类型
保存液
内含物
保存条件
运输条件
产品详细信息
Immunogen sequence: NDVHLRTPLL KENGDSEAGT EPGGPESTEA SSTSQAVEDC LHVRAIKTES SGLCQSSPGA QSSCSSEPSP LGSAPNNDSG VEMPGTGPGS LGDLTALDDT PPGADTSALA APSAGGLQLR KHMTTMHRFE QLKKEKLKSL KDSCSWAGPT PHTRNTKLPP LPGSGSILEN FSGSGGGGPA GLLPNPRLSE LSASE
靶标信息
Gli-2 belongs to the C2H2-type zinc finger protein subclass of the Gli family. Members of this subclass are characterized as transcription factors which bind DNA through zinc finger motifs. These motifs contain conserved H-C links. Gli family zinc finger proteins are mediators of Sonic hedgehog (Shh) signaling and they are implicated as potent oncogenes in the embryonal carcinoma cell. The protein encoded by this gene localizes to the cytoplasm and activates patched Drosophila homolog (PTCH) gene expression. It is also thought to play a role during embryogenesis. The encoded protein is associated with several phenotypes- Greig cephalopolysyndactyly syndrome, Pallister-Hall syndrome, preaxial polydactyly type IV, postaxial polydactyly types A1 and B.
仅用于科研。不用于诊断过程。未经明确授权不得转售。
篇参考文献 (0)
生物信息学
蛋白别名: GLI family zinc finger protein 2; GLI-Kruppel family member GLI2; glioma-associated oncogene family zinc finger 2; oncogene GLI2; Tax helper protein; tax helper protein 1; tax helper protein 2; tax-responsive element-2 holding protein; tax-responsive element-25-bp sequence binding protein; transcription factor; unnamed protein product; Zinc finger protein GLI2
基因别名: CJS; GLI2; HPE9; PHS2; THP; THP1; THP2
UniProt ID: (Human) P10070
Entrez Gene ID: (Human) 2736